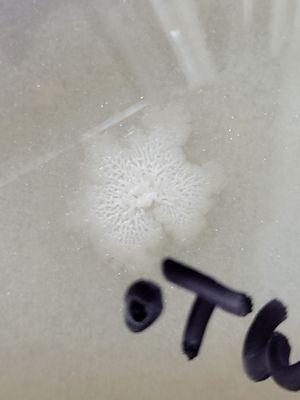
Serious bacterial to tenemation present in the sample brush out of the package.

Financial Partners Of TN
Closed
Advertisement
5731 Lyons View Pike Ste 107
Knoxville, TN 37919
Finance Partners Of Tennessee is a financial services firm based in Knoxville, TN. Specializing in a range of financial solutions, the company offers personalized advice and assistance to individuals and businesses seeking to manage their finances effectively.
With a focus on building long-term relationships with clients, Finance Partners Of Tennessee aims to provide reliable and trustworthy financial guidance to help clients achieve their goals. The firm's experienced team works closely with each client to develop tailored strategies that align with their unique financial needs and objectives.
Generated from their business information
Also at this address
See a problem?
You might also like
Partial Data by Foursquare.
Advertisement